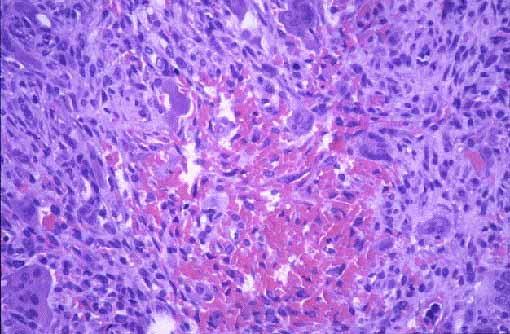
Fig 3

|
 |
|
Fig 1.- Radiografía simple del pie derecho. Lesión metafisio-diafisaria del tercer metatarso bien delimitada con trabeculación fina en su interior, adelgazamiento cortical y ausencia de esclerosis y de reacción periostal. |
Fig 2.- Proliferación reactiva de células de hábito fibroblástico y células gigantes, algunas de ellas intravasculares rodeadas de hueso reactivo neoformado (H&E, 100x). |
|
 |
|
Fig 3.- Abundantes células mononucleadas y gigantes multinucleadas rodeando a focos de hemorragia. Presencia de alguna mitosis en el componente mononuclear. (H&E, 200x). |
Fig 4.- Presencia de células gigantes multinucleadas intravasculares. (CD34, estreptavidina-biotina-fosfatasa alcalina, 200x). |
 |
|
Fig 5.- Positividad de las células gigantes para el anticuerpo CD68. (CD68 estreptavidina-biotina-fosfatasa |